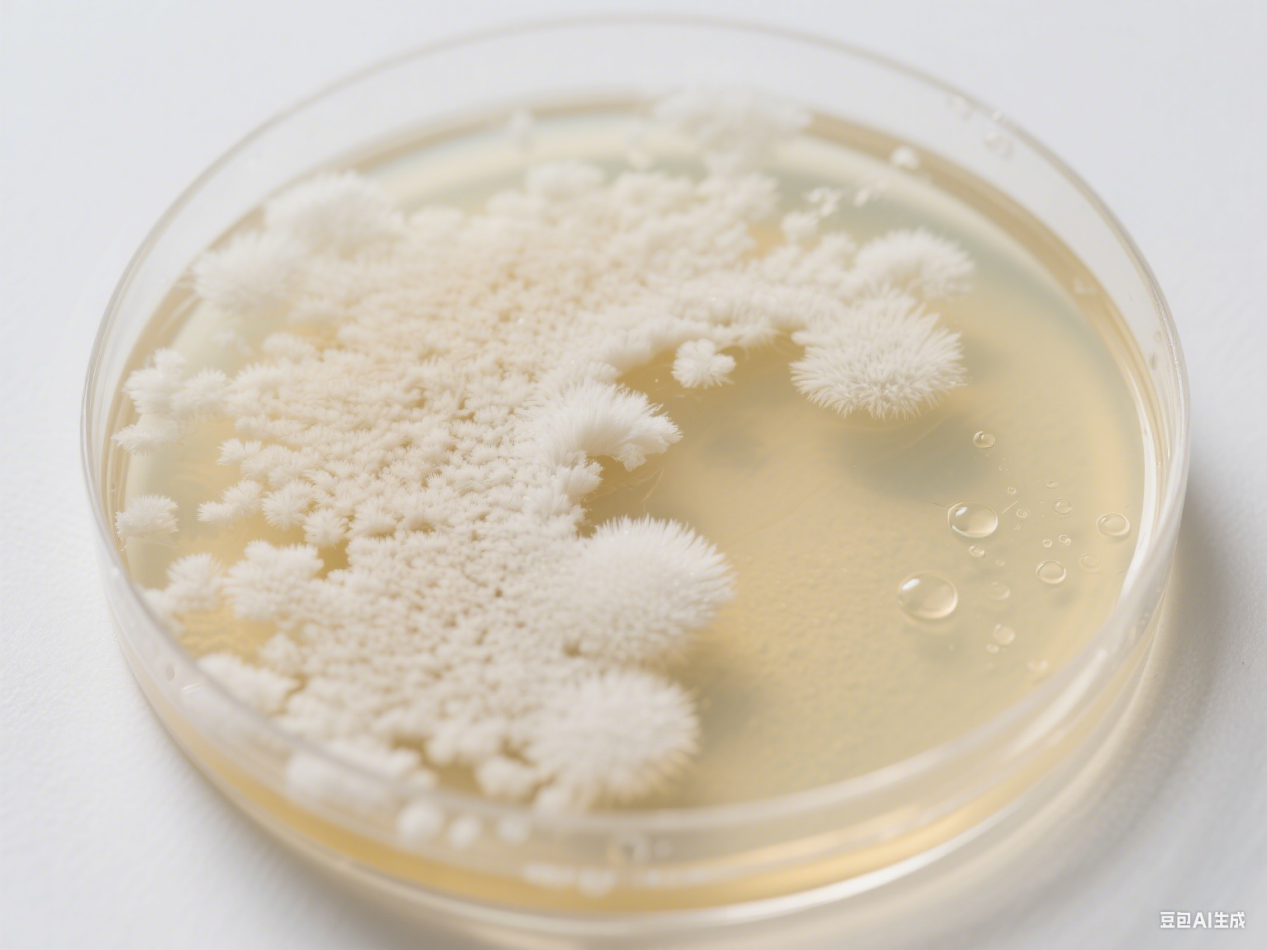
圖片2.png 圖片2.png

你有沒有在酸奶廣告里見過“添加嗜酸乳桿菌La-14菌株”?或者在腸道健康科普中聽到“雙歧桿菌屬的某些菌種能改善便秘”?這些“菌群”“菌屬”“菌株”……聽起來像繞口令的名詞,其實是科學家給微生物“分家譜”的專業術語。它們就像人類社會——看似復雜,實則邏輯清晰。今天,我們就來拆解這些概念,帶你讀懂微生物世界的“家族關系圖”。

從“單一個體”到“群體集合”:基礎概念先理清要理解這些關系,得先明確幾個最基礎的名詞:
菌體(Cell):這是最微觀的單位,指單個微生物細胞。比如一滴酸奶里,每一個活的乳酸菌就是一個菌體——它可能是一個球形、桿狀或螺旋狀的微小生命體,但單獨存在時,我們只能叫它“菌體”。
菌落(Colony):當大量同種菌體在固體培養基(比如實驗室的瓊脂平板)上生長繁殖時,會聚集成一個肉眼可見的“小疙瘩”,這就是菌落。比如你把口腔里的細菌涂在培養皿上,可能會長出白色、光滑的菌落(可能是鏈球菌),也可能有黃色、粗糙的菌落(可能是葡萄球菌)。一個菌落通常由同一個“祖先”菌體分裂增殖而來,代表同一類微生物的集合,但它還不是嚴格的分類學概念,更像實驗室里的“觀察單位”。
2
分類學階梯:從“屬”到“株”的科學命名體系微生物和人類一樣,需要一套科學的“族譜”來區分不同種類。科學家用“界門綱目科屬種”的分類系統(和動植物類似),其中和日常最相關的是菌屬、菌種、菌株這三個層級:
菌屬(Genus):同一“大家族”“屬”是較大的分類單元,包含一群具有共同特征的微生物。比如“雙歧桿菌屬(Bifidobacterium)”里的所有細菌,都有桿狀外形、能發酵糖類產酸、對腸道健康有益的共同特點;再比如“鏈球菌屬(Streptococcus)”的成員,通常是球形且成鏈狀排列。舉個例子:酸奶里常提到的“保加利亞乳桿菌”和“嗜熱鏈球菌”,前者屬于“乳桿菌屬”,后者屬于“鏈球菌屬”——它們連“屬”都不同,屬于微生物界的“遠親”。
菌種(Species):同一“家庭”的核心成員“種”是分類學上最基本的自然單元,指能夠相互交配并產生可育后代的一群微生物(雖然細菌不通過有性繁殖,但有類似的遺傳相似性標準)。同一菌種的微生物,遺傳背景高度相似(通常DNA相似度>97%),且具有穩定的生物學特性。繼續用酸奶舉例:保加利亞乳桿菌的全稱是“德氏乳桿菌保加利亞亞種”——這里“乳桿菌屬”是大家族,“德氏乳桿菌”是更具體的“家庭”(種級分類),而“保加利亞亞種”是這個家庭下的分支(亞種,比種更細的分類)。簡單來說,“種”就像人類的“黃種人”“白種人”,是同一大群體中特征明確的細分單元。
3. 菌株(Strain):同一“家庭”里的“個體差異”“菌株”是同一菌種下,因遺傳變異或人工選育形成的具體“個體”。即使是同一個菌種(比如“嗜酸乳桿菌”),不同來源(比如從人體腸道分離的 vs 從發酵食品中分離的)或經過不同實驗室培育的菌體,可能在功能上有顯著差異——有的更耐胃酸,有的產更多益生菌代謝物。這些差異明顯的個體,就被命名為不同的“菌株”,并用字母+數字標記(如“嗜酸乳桿菌La-14”“鼠李糖乳桿菌GG”)。關鍵區別:同一菌種的不同菌株,可能效果天差地別!比如研究顯示,某些菌株的“嗜酸乳桿菌”能顯著改善腹瀉,而另一些菌株可能效果微弱甚至無效。這也是為什么保健品或酸奶會特別標注“XX菌株”——因為功能是由具體的“菌株”決定的,而不是籠統的“菌種”。
宏觀視角:菌群與菌落的關聯
1. 菌群(Microbiota/Microbial Community):微生物的“生態系統”“菌群”指的是特定環境中所有微生物的集合,包括細菌、真菌、病毒等,且涵蓋多個菌屬、菌種甚至菌株。比如:
人體腸道菌群:包含500-1000種微生物,涉及雙歧桿菌屬、乳桿菌屬、腸球菌屬等多個菌屬,每個菌屬下又有幾十種菌種,每種菌種又包含多個菌株;
土壤菌群:有分解有機質的放線菌、固氮的根瘤菌等,它們共同維持生態功能。
菌群強調“多樣性”和“協同作用”——就像一座城市或完整的生態系統。既有不同的村莊,住著不同的民族,擁有無數個家庭,它們群體生活在一起相互影響,共同維持系統的穩定。
2. 菌落(Colony):實驗室里的“觀察窗口”前面說過,菌落是單個菌體在培養基上繁殖形成的肉眼可見集合。但在自然環境中(比如腸道或土壤),微生物不會孤立生長成“菌落”,而是形成復雜的菌群。實驗室通過培養單個菌體得到菌落,是為了研究某個菌種或菌株的特性(比如它能不能耐受高溫、能不能產生抗菌物質)。

總結:一張圖看懂它們的關系如果用“人類社會”類比,邏輯會更清晰:
菌體 → 單個人(一個微生物細胞)。
菌落 → 由同血緣家族發展而成村莊。
菌種 → 一個具有共同遺傳特征的民族。
菌屬 → 包含多個民族的國家。
菌株 → 民族中的具體獨特技能或特征的家庭或個體(比如擅長釀酒的張家)
菌群 → 由無數個村莊、民族、家庭共同居住和互動的整個城市或生態系統。
為什么這些概念重要?理解這些關系,能幫我們更科學地看待微生物相關產品:
選益生菌時,別只看“雙歧桿菌屬”或“乳酸菌種”,要關注具體菌株編號;
研究土壤健康時,“菌群失衡”比單一菌種減少更重要——因為菌群是多種微生物協同的結果;
實驗室里,科學家通過分離特定菌落,培養純化的菌株,才能精準研究其功能。
下次再看到“XX菌屬的XX菌種XX菌株”,你就能輕松拆解它的“身份密碼”啦!微生物的世界雖小,卻有著嚴謹的“家族邏輯”——而這,正是科學探索的魅力所在。
關于我們
北京鴻潤寶順科技有限公司創建于2008年,位于北京自由貿易試驗區科技創新片區,是一家以蛋白胨、大豆蛋白胨、胰蛋白胨、酵母浸粉、牛肉浸粉等微生物培養基原材料和發酵原料為主,集研發、生產、銷售為一體的現代化高新技術企業。2020年在四川省閬中市建立生產基地。產品供應國內所有微生物培養基行業產區,為行業企業提供大量生物發酵所需的有機氮源原料。公司不斷創新技術、調整配方、升級工藝,用更好的產品助力行業發展。

文章來源網絡轉載由微信公眾號“戈舟老師 戈舟說農事 ”原創,是出于傳遞更多信息之目的,非本平臺觀點。若有來源標注錯誤或侵犯了您的合法權益,請及時與我們聯系,我們將及時更正、刪除。